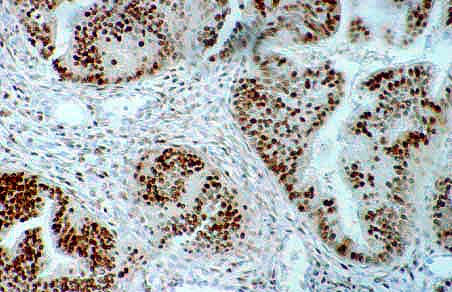
fig_7.jpg (27693 bytes)

Dra. Teresa Garcia Miralles
|
 |
[ëndice] [Introducciµn] [Facts. 1ˆ Gen.] [Facts. 2ˆ Gen.] [IconografÚa] [Conclusiones] [Protocolo] [BibliografÚa] |
|
Fig 7.- La presencia de Receptores Hormonales (RE/RP) pueden estar presentes tanto en el componente glandular como estromal del tejido endometrial normal y neoplasico.Tincion de Avidina -Estreptovidina X 200. |
 |
Fig 8.- Positividad en el estroma para RE en un adenocarcinoma endometrioide bien diferenciado. Negatividad de la glÃndula acompaþante.Tincion de Avidina -Estreptovidina X 200. |

|
Fig 9.- Presencia de RP en un adenocarcinoma endometrioide bien diferenciado. Grado 1 nuclear.Tincion de Avidina-Estreptovidina X 200. |
 |
Fig 10.- Hiperexpresion de la proteÚna p53 en un Ãrea sµlida de un Ca endometrioide Grado III de diferenciaciµn, Grado 3 nuclear.Tincion de Avidina-Estreptovidina X 400. |
 |
Fig 11.- El protooncogen Her-2 neu es positivo en este Ca endometrioide de alto Grado de Malignidad. ObsÕrvese el patrµn caracterÚstico de membrana.Tincion de Avidina -Estreptovidina X 400. |
 |
Fig 12.-Presencia de Her-2 neu en un Adenocarcinoma de CÕlulas Claras.Tincion de Avidina-Estreptovidina X 400. |
 |
Fig 13.- Factor de Proliferaciµn (MIB-1) positivo en los nºcleos de un Ca endometrioide Grado III.Tincion de Avidina-Estreptovidina X 400. |
[ëndice] [Introducciµn] [Facts. 1ˆ Gen.] [Facts. 2ˆ Gen.] [IconografÚa] [Conclusiones] [Protocolo] [BibliografÚa] |